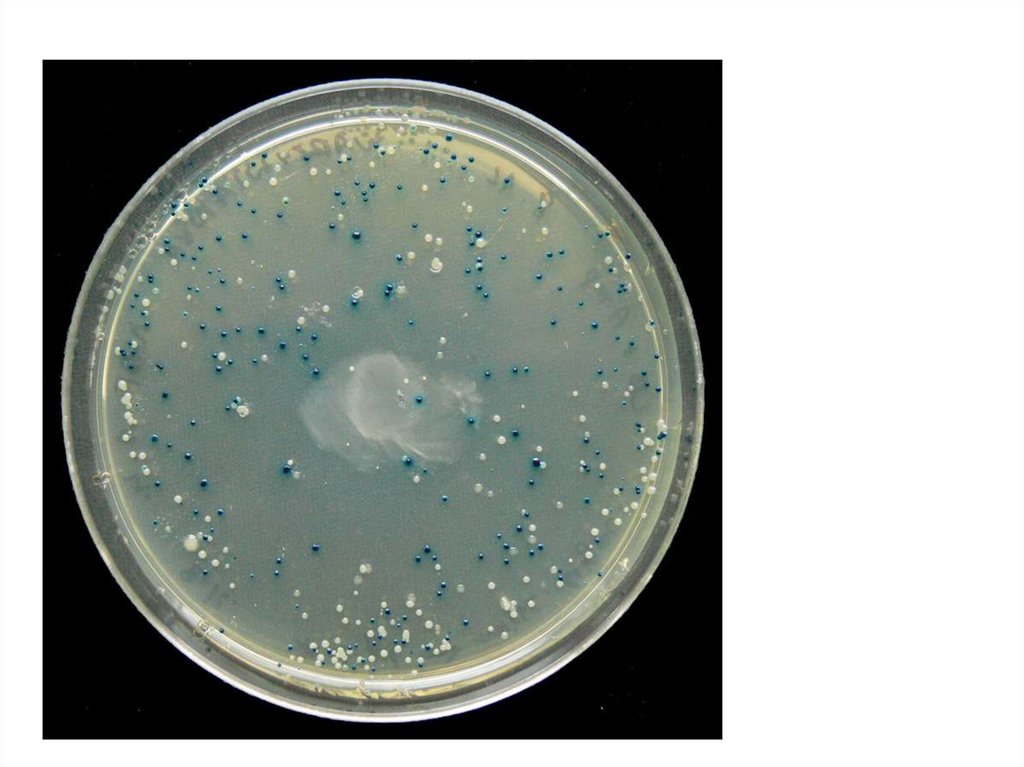

Similar presentations:
Трансгенные растения
1.
2.
Что нужно, чтобы получитьтрансгенное растение?
3.
Чужеродная ДНК должна проникнуть в клетку«Избавление» от клеточной стенки
4.
Бомбардировка клеток5.
Использование потенциала фитопатогенов6.
Нужно чтобы целевой участок ДНК:Встроился в геном
Экспрессировался (чтобы генетическая
информация считывалась)
7.
Чужеродные гены находятся в составевекторных плазмид
8.
Введение векторных конструкций в клеткирастений
Станет ли после этого растение трансгенным?
9.
Регенерацияцелых растений из
отдельных
трансформирован
ных клеток
10.
Основной подход для созданиятрансгенных растений
11.
Корончатые галлы12.
Корончатые галлы13.
Agrobacterium tumifaciens14.
Agrobacterium tumifaciens15.
Интеграция тДНК в геном растения16.
Модификация Ti – плазмиды для созданиятрансгенных растений
17.
Модификация Ti – плазмиды для созданиятрансгенных растений
Ген, который хотят
встроить
Селективный
маркер
18.
Бинарный вектор19.
20.
Введение векторных конструкций в клеткирастений
21.
Регенерация целых растений из отдельныхтрансформированных клеток
22.
Модификация Ti – плазмиды для созданиятрансгенных растений
Ген, который хотят
встроить
Селективный
маркер
23.
Откуда берут целевой фрагмент ДНК,который хотят встроить в
растительный геном?
24.
25.
ПЦР (полимеразная цепнаяреакция) – метод
селективной амплификации
участка ДНК in vitro
26.
Компоненты реакции:Вода
Буфер для фермента (Taqполимеразы)
Дезоксинуклеотид фосфаты
Праймеры (прямой и обратный)
Фермент (Taq-полимераза)
ДНК-матрица
27.
28.
29.
30.
31.
32.
Конструирование праймеров33.
34.
35.
36.
37.
38.
39.
Характеристики праймеровКомплементарность мишени
Высокое GC содержание
На 3’-конце праймера G или С
Температура отжига 55-60° С
Отсутствие вторичных структур (шпилек и димеров)
40.
41.
42.
BLAST43.
44.
Что обычно используется в качестве матрицы(основы) для амплификации «нужного» участка
ДНК?
45.
46.
47.
48.
Мы провели ПЦР, чтобы получить целевой фрагмент ДНКНужно выяснить получился ли у нас ожидаемый продукт
Электрофорез
49.
Электрофоретическоеразделение нуклеиновых кислот
50.
Электрофорез ДНК в агарозном геле51.
Электрофорез белков52.
Разделение молекул в электрическом поле53.
Разделение макромолекул взависимости от:
размера,
пространственной конфигурации,
электрического заряда
54.
Разделение проводят в полиакриламидном гелеАкриламид
(СН2 = СН — CONH2)
NN'-Метиленбисакриламид
(CH2 = CH — CONH)2 – СН2
Буферные растворы
55.
Индукция полимеризации акриламидаПерсульфат аммония
56.
Полимеризация акриламида57.
Катализатор процесса полимеризацииТетраметилэтилендиамин (ТЕМЕД) — (СН3)2N — CH2 — CH2 — N(СН3)2
58.
Денатурация белка с помощью ДДС59.
60.
61.
Постоянная сила токаВысокая напряженность
Низкая напряженность
Подвижность ионов
Заряд ионов
Изоэлектрическая точка
62.
Глицин – малоподвижный ион. Высокоесопротивление. Высокая напряженность
Б
Хлор – подвижный ион. Низкое сопротивление.
Низкая напряженность
Одинаковая сила тока
А
Суммарное напряжение распределится между участками А и Б так, что
напряженность поля А будет выше, причем настолько, чтобы скорость
миграции ионов глицина стала точно такой же как у ионов хлора. Этого
требует условие неизменности величины тока вдоль всего геля
(постоянство тока во всем геле).
63.
64.
Двумерный электрофорез белков65.
66.
67.
Векторные конструкции68.
Рестриктазы69.
Сборка плазмиды. Рестрикция-лигирование.70.
71.
Векторы для клонированияX-Gal
72.
73.
Векторы для экспрессии74.
75.
76.
Лизис клеток77.
Очистка целевого белкаХроматография
78.
79.
80.
81.
82.
83.
Векторы для трансформации растений84.
85.
Определение первичной структуры ДНК86.
87.
88.
89.
90.
ATGCTACTACGATG
ATGCTAC
TACGATG
ATGCTAC
TACGATG
ATGCTAC
TACGATG
ATGCTAC
TACGATG
ATGCTAC
TACGATG
ATGCTAC
TACGATG
TACGATG
A*
TACGATG
TACGATG
AT*
TACGATG
TACGATG
ATG*
TACGATG
Денатурация,
отжиг праймера
Элонгация
TACGATG
ATGC*
TACGATG
TACGATG
ATGCT*
TACGATG
TACGATG
ATGCTA*
TACGATG
TACGATG
ATGCTAC*
TACGATG
91.
92.
93.
A*TACGATG
AT*
TACGATG
A T
ATG*
TACGATG
ATGC*
TACGATG
ATGCT*
TACGATG
ATGCTA*
TACGATG
ATGCTAC*
TACGATG
Капиллярный
электрофорез
C
A
T
C
G
T
A
Анализ
G
C T
A
С

biology
biology








